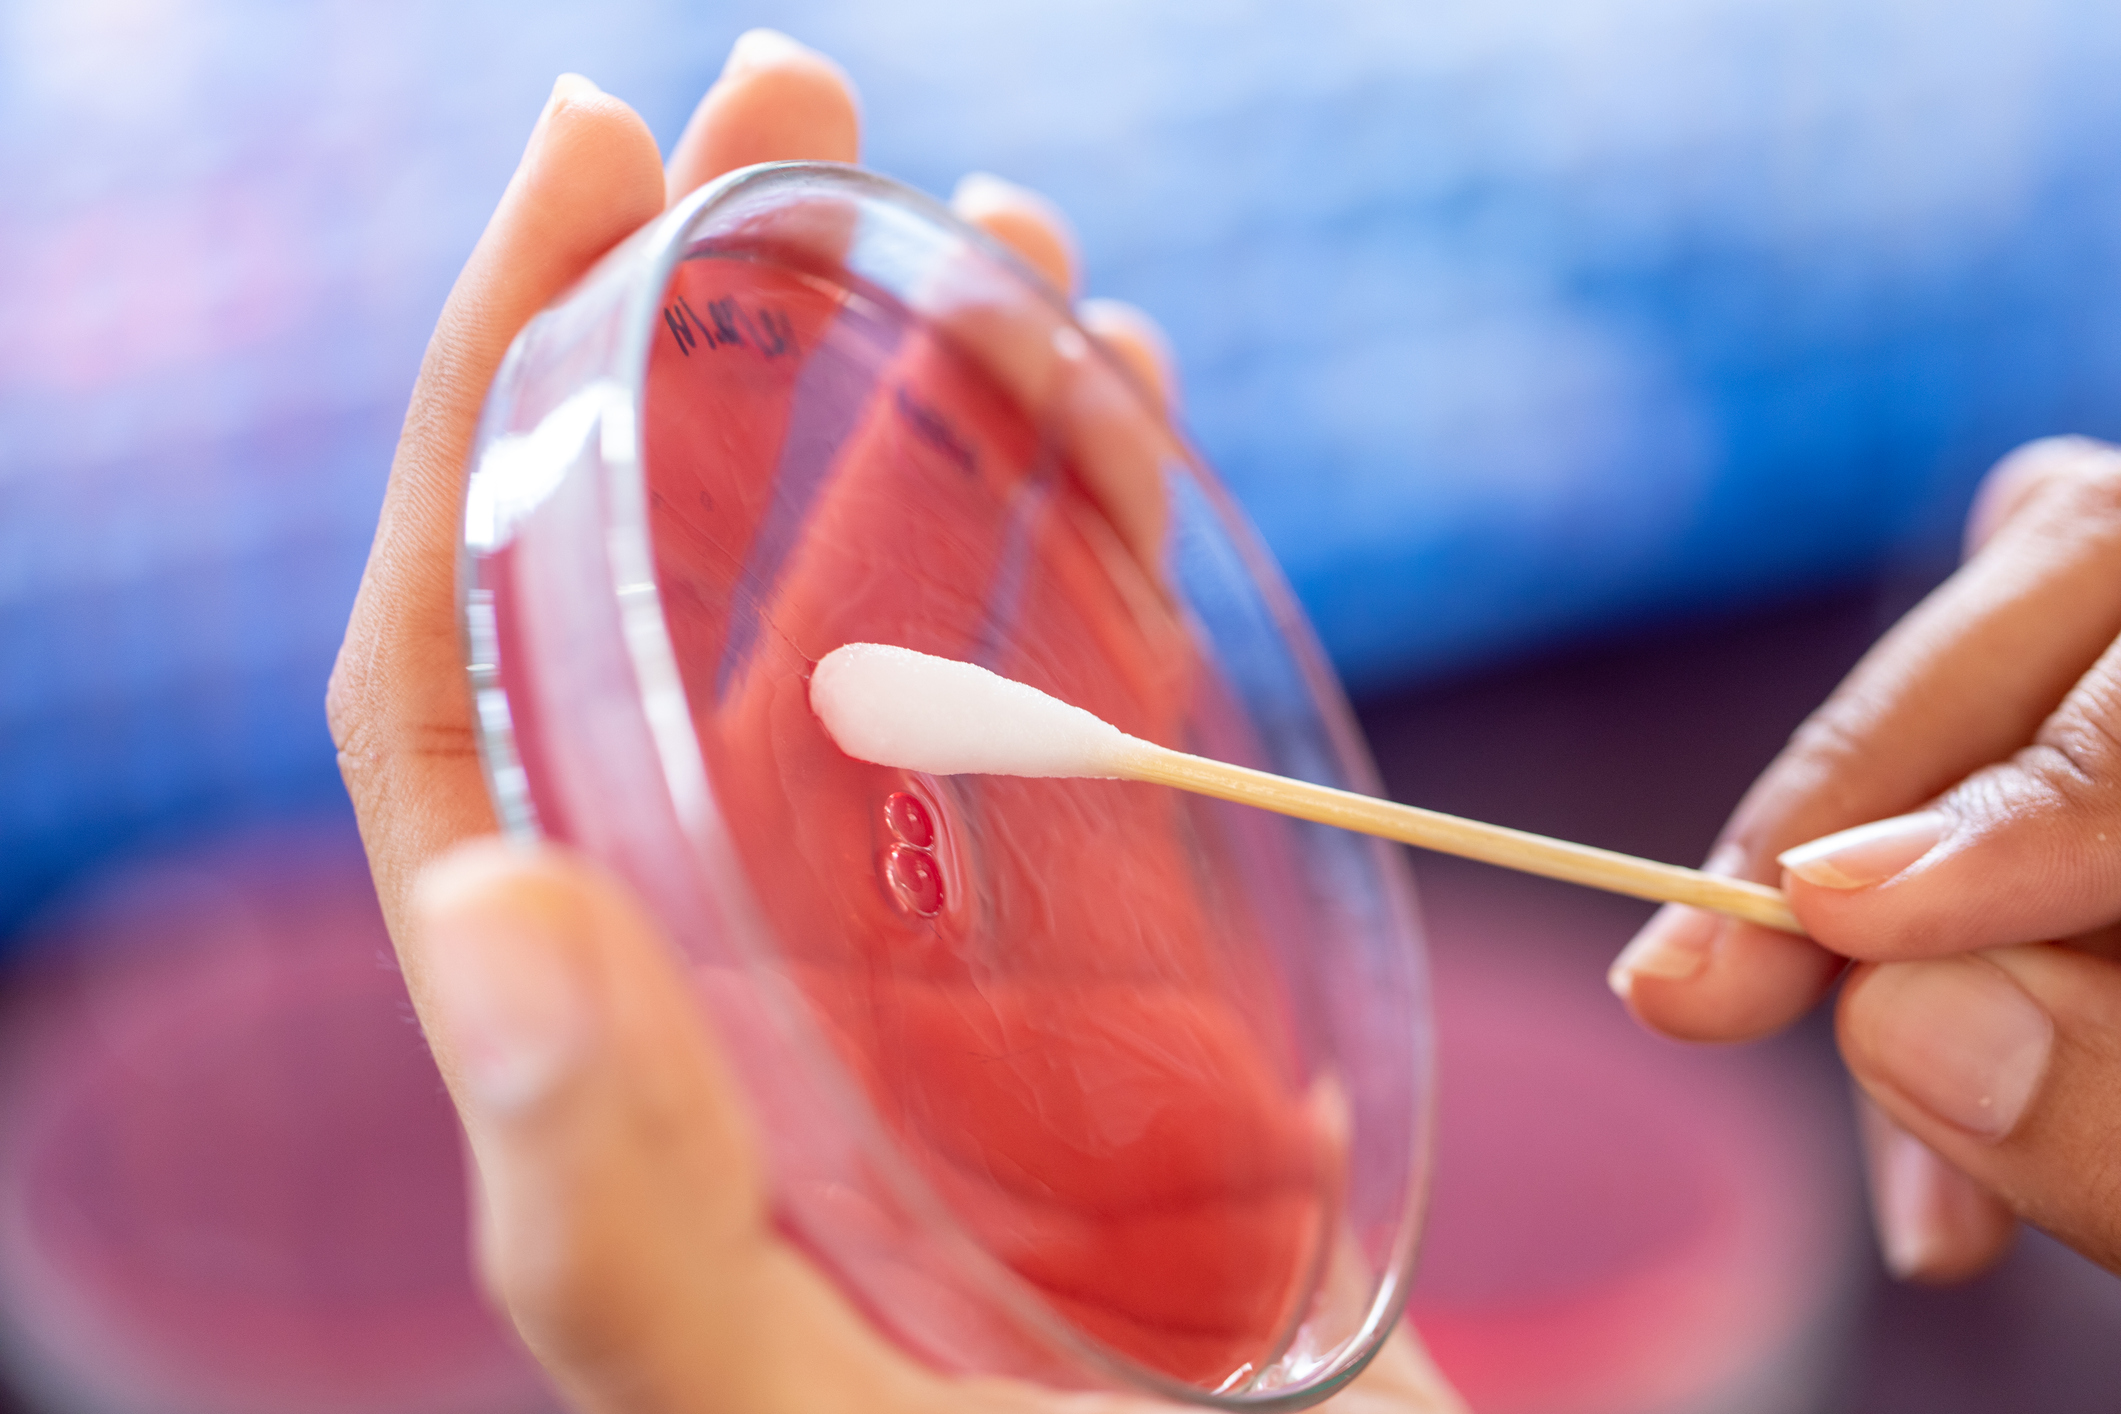

All - 249 available

Aspergillus Culture
- Price: £28
- Species: Canine, Feline, Rabbit, Small mammal, Exotics (non-mammal), Equine, Avian, Primate
- Test Type: Microbiology
- Sample Type: Fluid, Swab, Tissue (fresh)

Avian circovirus PCR*
- Price: £73.50
- Species: Avian
- Disease / Presentation: Systemic disease
- Test Type: PCR
- Sample Type: Faeces

Avian polyomavirus PCR*
- Price: £67.20
- Species: Avian
- Disease / Presentation: Skin / Aural disease
- Test Type: PCR
- Sample Type: Feather

Babesia PCR*
- Price: £63
- Species: Canine
- Disease / Presentation: Haematological disease
- Test Type: PCR
- Sample Type: Blood - clotted (red top)

Bacteriology - aerobic culture only
- Price: £35.50
- Species: Rabbit, Small mammal, Exotics (non-mammal), Equine, Avian, Primate, Canine, Feline
- Test Type: Microbiology
- Sample Type: Fluid, Swab, Tissue (fresh)
Bacteriology aerobic & anaerobic culture
- Price: £40.70
- Species: Rabbit, Small mammal, Exotics (non-mammal), Equine, Avian, Primate, Canine, Feline
- Test Type: Microbiology
- Sample Type: Fluid, Swab, Tissue (fresh)
